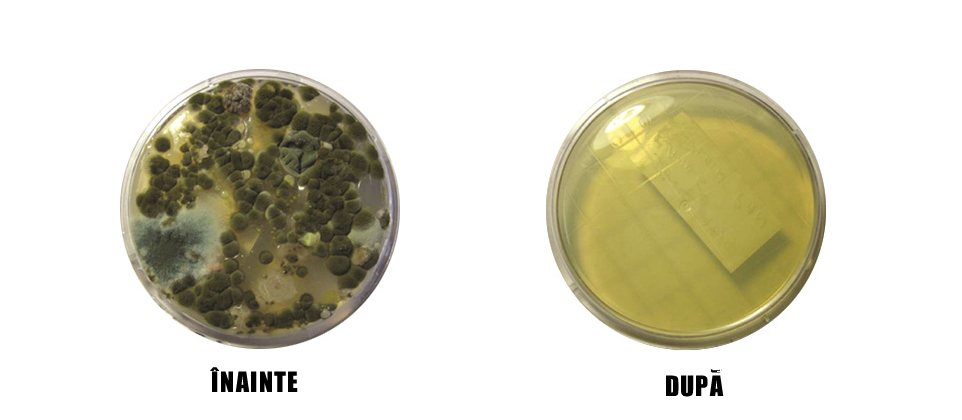
Inainte steril aire

BACTERIILE ȘI MUCEGAIURILE CAUZATOARE DE INFECȚII NOSOCOMIALE SE DEZVOLTĂ AICI.

Aerul care trece prin componentele murdare ale sistemului de aer conditionat
(de mai sus), poate răspândi contaminarea în întreaga clădire.
Unitatea HVAC din spital este un rezervor, amplificator și distribuitor de microorganisme atribuite în mod obișnuit infecțiilor nosocomiale. Aceste microorganisme contribuie la creșterea materialului microbiologic complex numit „biofilm” (de mai sus), care aderă la vaporizatoarele HVAC și la tăvile de scurgere. Studiile privind calitatea aerului arată că aceste microorganisme problematice sunt distribuite și sunt prezente în aer, putând fi inhalate de către pacienți, crescând riscul infecțiilor nosocomiale. Filtrarea aerului și curățarea regulată a acestora sunt insuficiente. Solutia este de a aborda cauza principala de contaminare la sursă.


SOLUȚIA
ECHIPAMENTELE CU RADIAȚIE ULTRAVIOLETĂ GERMICIDALĂ – UVGI
DE LA STERIL-AIRE OFERĂ SPITALELOR TREI AVANTAJE VIABILE

Culturile de laborator de dinainte și de după luate din sistemele HVAC
din spital arată impactul antimicrobian al UVGI(iradierea cu raze ultraviolete germicidale)
de la Steril-Aire
Mulți clinicieni și specialiști în prevenirea infecțiilor sunt surprinși să afle că sistemele de aer condiționat din spitale sunt rezervoare
de microorganisme care provoacă infecții nosocomiale. Unde este dovada? Cât de răspândită este aceasta?
Cum știu că Steril-Aire funcționează? Luăm o abordare bazată pe dovezi, care include analiza culturilor luate de pe suprafețele echipamentelor
de aer condiționat înainte și după instalare. Această analiză calitativă și cantitativă validează eficacitatea noastră.
AVANTAJELE
4 MOTIVE PENTRU CARE SOLUȚIA UVGI STERIL-AIRE ESTE CEA MAI BUNĂ

- 1.Randamentul ridicat înseamnă o acțiune antimicrobiană prelungită
Pentru inactivarea unui minim de 99,9% din microorganisme este necesară o doză specifică de energie UVGI. S-a dovedit că emițătoarele Steril-Aire UVGI pot susține intensități mai mari pe o perioadă mai lungă de timp, în comparație cu produsele firmelor concurente.
- 2.Sistemele proiectate pentru a penetra fiecare cavitate
Sistemele Steril-Aire sunt proiectate să pătrundă în fiecare colț și adâncitură în care ar putea să crească microorganismele. Noi optimizăm performanța prin asigurarea unui nivel adecvat de energie UVGI pentru a satisface nivelul necesar de dezactivare microbiană.
- 3.Testările independente demonstrează performanțele superioare.
Testările independente au dovedit că emițătoarele noastre ofere de până la 7 ori mai multă energie decât produsele competitorilor și au o durată de viață de 4 ori mai mare în mediul rece și umed HVAC.
- 4.Tehnologia patentată este de multe ori copiată, niciodată duplicată
Steril-Aire a inventat tehnologia UVC pentru HVAC ™ în urmă cu 20 de ani și a continuat să o dezvolte. Imitatorii nu au fost niciodată capabili să egaleze originalul, care includ proiectare și manufacturare superioară.
Contact Steril Aire Romania




